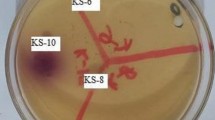

Abstract
Purpose
Multi-species probiotic preparations have been suggested as having a wide spectrum of application, although few studies have compared their efficacy with that of individual component strains at equal concentrations. We therefore tested the ability of 4 single probiotics and 4 probiotic mixtures to inhibit the urinary tract pathogens Escherichia coli NCTC 9001 and Enterococcus faecalis NCTC 00775.
Methods
We used an agar spot test to test the ability of viable cells to inhibit pathogens, while a broth inhibition assay was used to assess inhibition by cell-free probiotic supernatants in both pH-neutralised and non-neutralised forms.
Results
In the agar spot test, all probiotic treatments showed inhibition, L. acidophilus was the most inhibitory single strain against E. faecalis, L. fermentum the most inhibitory against E. coli. A commercially available mixture of 14 strains (Bio-Kult®) was the most effective mixture, against E. faecalis, the 3-lactobacillus mixture the most inhibitory against E. coli. Mixtures were not significantly more inhibitory than single strains. In the broth inhibition assays, all probiotic supernatants inhibited both pathogens when pH was not controlled, with only 2 treatments causing inhibition at a neutral pH.
Conclusions
Both viable cells of probiotics and supernatants of probiotic cultures were able to inhibit growth of two urinary tract pathogens. Probiotic mixtures prevented the growth of urinary tract pathogens but were not significantly more inhibitory than single strains. Probiotics appear to produce metabolites that are inhibitory towards urinary tract pathogens. Probiotics display potential to reduce the incidence of urinary tract infections via inhibition of colonisation.
Similar content being viewed by others
Avoid common mistakes on your manuscript.
Introduction
Probiotics are defined as live organisms which, when administered in sufficient amounts, can have a beneficial effect on host health [1]. They have shown effectiveness in a range of conditions including travellers’ diarrhoea, antibiotic-associated diarrhoea [2], upper respiratory tract infections [3], Helicobacter pylori infections [4], atopic dermatitis [5, 6] and some inflammatory conditions [7, 8], although there are species- and strain-specific aspects to their activities [9, 10]. Potential mechanisms of action include modulation of the intestinal immune system and displacement of potential pathogens via competitive exclusion [10] or production of antimicrobial agents including organic acids such as lactic and acetic acids [11] and heat-stable peptide bacteriocins [12]. In a recent study, we found that despite the potential for probiotics within a mixture to inhibit each other, in many cases, probiotic mixtures were as effective as, or more effective than, their single-strain components at inhibiting gastrointestinal pathogens.
Urinary tract infections (UTI) are the most common bacterial infections [13] affecting one woman in three during her lifetime [14]. Causative organisms include Klebsiella pneumoniae, Gardnerella vaginalis [15], Pseudomonas aeruginosa, E. faecalis, Staphylococcus epidermidis. Uropathogenic E. coli (UPEC) is generally regarded as the most common causative species, with these strains differing from commensal strains via their virulence factors such as toxins and fimbriae used for adhesion to host cells [16]. The prevention of UTI is generally seen as difficult [17], and standard treatment is by antibiotic therapy such as metronidazole [18, 19]. In female populations, UTI are generally characterised by abnormal vaginal microbiota [20] among other symptoms. Analysis of the vaginal flora of healthy women has revealed that up to 79 % have high levels of lactobacilli [21, 22], and the lowest prevalence of bacterial vaginosis (BV) has been correlated with colonisation of hydrogen peroxide-producing lactobacilli [23].
The use of probiotics as an alternative or adjunctive treatment for UTI has been investigated for over a decade. The rationale for this is several-fold. Firstly, the increasing antibiotic resistance of uropathogenic species [24], coupled with the fact that lactobacilli are resistant to Vancomycin [20], suggests a treatment which takes these issues into account. The lack of side effects with probiotic treatment [25] alongside the frequency of UTI recurrence [26] may indicate a treatment which can be used more frequently and more safely.
Various criteria have been postulated for the efficacy of probiotics in the treatment of UTI [27], and favourable results have been seen using probiotics as a treatment alongside antibiotics to treat UTI and restore a healthy vaginal microbiota [18, 19] and also with probiotics alone. For example, Anukam et al. used probiotics used as both an effective adjunct [19] and alternative [18] to traditional antibiotic therapy for UTI. Locally applied probiotics such as Lactobacillus rhamnosus GR-1, L. fermentum RC-14 [28] and L. acidophilus 61701 [22] have been shown to both colonise the vaginal area and reduce recurrence of BV [15]. Further to this, orally administered probiotics have been shown to colonise the vagina [28], possibly via the gut as a reservoir prior to vaginal colonisation [23]. Probiotics have also been observed to restore a more lactobacillus-dominant microbiota in the vagina [25].
Given the species-specific effect of probiotics in their inhibition of pathogens, it is reasonable to hypothesise that different probiotics might have a variety of effects against different urogenital pathogens. Because some of the strains used in our previous study [29] demonstrated inhibitory effects against gastrointestinal pathogens, it is suggested that some of these strains may display similar patterns of inhibition towards uropathogens. Further, since different orally administered probiotics show different patterns of vaginal colonisation [25], it can be hypothesised that a mixture of probiotic species may be more effective at inhibiting UTI-causing species.
In a recent review [30], it was noted that many studies comparing the effectiveness of single- and multi-species probiotics were confounded due to the use of probiotic treatments at different cell densities. Since optical density (OD) is used as a rapid measurement of bacterial biomass [31], in this study for the agar spot test, we used the method of equalising the OD at 650 nm (OD650) to provide treatments of approximately equal cell densities for both the mixtures and single strains.
This study had several aims. The first was to test the in vitro effectiveness at inhibiting two uropathogens of four potential probiotics (for brevity’s sake, these will henceforth be referred to as ‘probiotics’.). The second was to compare the inhibitory effect of these strains in various mixtures containing these strains at equal cell densities and to attempt to correlate levels of acid production between these single- and multi-strain probiotics, with inhibition of uropathogens. A broth inhibition assay was used to establish levels of growth inhibition of such pathogens in the presence solely of both neutralised and non-neutralised probiotic supernatants, obviating competition for nutrients and pH-lowering effects as potential causes of inhibition.
Materials and methods
Microorganisms used
Probiotics used were L. acidophilus NCIMB 30184 (PXN 35), L. fermentum NCIMB 30188 (PXN 54), L. plantarum NCIMB 30187 (PXN 44) and L. rhamnosus NCIMB 30226 (PXN 44). The following mixtures were tested: 2 lactobacilli mixture (L. acidophilus and L. plantarum), 3 lactobacilli mixture (L. acidophilus, L. fermentum and L. rhamnosus), 4 lactobacilli mixture (L. acidophilus, L. fermentum, L. rhamnosus and L. plantarum), and the commercially available Bio-Kult® mixture. Its constituent strains are, at various percentages of total volume, L. acidophilus, L. delbrueckii subsp. bulgaricus, L. casei, L. plantarum, L. rhamnosus, L. salivarius ssp. salivarius, L. helveticus, B. bifidum, B. breve, B. infantis, B. longum, Str. thermophilus, Lactococcus lactis, Bacillus subtilus.
Pathogens tested were Enterococcus faecalis NCTC 00775 and E. coli NCTC 9001.
Agar spot test
The method used by Barbosa et al. [32] was adopted. Probiotic strains were cultured overnight in de Man Rogosa Sharpe (MRS) broth. Overnight cultures were then adjusted to optical density 0.8 at 650 nm. In preliminary studies of OD versus viable counts, an OD of 0.8 corresponded to 5–8 × 107 CFU/ml. Mixtures were made using equal volumes of component strain cultures so that the final OD of both the single strains and the mixtures was 0.8. Probiotics were then spotted onto plates of MRS agar (Oxoid, Basingstoke, United Kingdom) in 5-μl aliquots—these spots represented the test strain or mixture. After 24-h incubation at 37 °C in anaerobic conditions (DW Scientific, Shipley, UK), these plates were overlaid with 0.7 % (w/v) pathogen-appropriate agar inoculated with 5 μl of overnight culture of the respective pathogen. After 24-h incubation at 37 °C in an aerobic atmosphere, zones of inhibition were measured. A clear ring around the spotted test strain was taken to indicate the zone of inhibition. Mean inhibition scores for each probiotic preparation were taken to give an indication of that preparation’s inhibitory nature, relative to the others tested.
Detection of acid production
Overnight cultures of probiotics and mixtures were centrifuged for 10 min at 2,050×g, then filter-sterilised using 2-μm filters (Whatman, Maidstone, United Kingdom). The pH of the resulting culture supernatant was measured (Mettler Toledo, Leicester). The change in pH was expressed as the pH of the culture supernatant subtracted from the pH of unused MRS broth.
Broth inhibition assay
Overnight cultures of probiotics in MRS broth, incubated as above, were centrifuged at 2,050×g for 10 min. The resulting supernatant was removed and the pellet discarded. Half of each supernatant was neutralised to pH7 using 1-M sodium hydroxide. Neutralised and non-neutralised supernatants were frozen in aliquots until use and defrosted overnight at room temperature before use. Pathogens were cultured overnight at 37 °C under aerobic conditions in nutrient broth for E. coli and Tryptone Soy broth for E. faecalis. An aliquot (5 μl) of the overnight cultures was added to 9 ml of fresh broth and 1 ml of the cell-free probiotic supernatant was added to each pathogen culture. This was carried out using both neutralised and non-neutralised supernatants for each probiotic treatment to account for pH-lowering effects of the probiotics as a potential mechanism of inhibition. OD650 (254 Colorimeter, Sherwood Scientific, Cambridge, UK) was measured at 0, 4 and 8 h to determine inhibition of pathogen growth compared with a negative control containing broth culture of pathogen with no added supernatant. At time points 8 h and 24 h, serial dilutions were performed and viable counts of each culture determined.
Statistical analysis
For the agar spot test, one-way analysis of variance (ANOVA) was performed with post hoc tests for least significant difference to determine the effect on the size of inhibition zone of single- or multi-strain treatments. Further analysis of variance with post hoc tests for least significant difference was performed to rank performances of each probiotic mixture against all pathogens.
For the broth inhibition assay, a two-way ANOVA was fitted, using time and treatment as fixed factors. As expected, in both models, time was highly significant. Treatment was also significant overall. Further analysis was done using Dunnett’s test to compare each treatment with the control.
For both tests, p values of < 0.05 were considered significant. Calculations were made using the SPSS software, v.18 (Chicago, ILL, USA).
Results
Agar spot test
Testing against E. coli
Mean zones of inhibition for four single-strain probiotics (8.3–16.3 mm) and the four mixtures (5.7–20.3 mm) tested against E. coli are shown in Fig. 1. The most inhibitory single strain compared with control was L. fermentum (p < 0.01), while the most inhibitory mixture was the 3-lactobacillus mixture (mean inhibition zone 20.3 mm, p < 0.01). Initial analysis suggested that a single-strain preparation was more effective than a probiotic mixture, although ANOVA determined that this difference was not significant.
Figure 2 shows mean inhibition zone diameter plotted against acid production by probiotic treatments. An R 2 value of 0.1425 was obtained, suggesting a weak correlation between acid production by a probiotic treatment, and its ability to inhibit this strain of E. coli.
Testing against E. faecalis
Figure 3 shows the mean zones of inhibition of the four single-strain probiotics and the four mixtures when tested against E. faecalis. Single- and multi-strain probiotic treatments produced a similar range of inhibition zones. Initial analysis revealed that L. acidophilus appeared to be the most effective inhibitor of E. faecalis (mean inhibition zone 9.2 mm), but this difference was not significant. Bio-Kult® was significantly (p < 0.01) the most inhibitory mixture (9.6 mm). Mixtures (mean inhibition 8.0 mm) exhibited a similar inhibitory activity as single strains (7.6 mm).
Figure 4 shows mean inhibition zone diameter plotted against production of acid by probiotic treatments. There was an R 2 value of 0.237, suggesting a very weak correlation between the acid production of a probiotic treatment and its inhibition of E. faecalis NCTC 00775.
Table 1 shows results of ANOVA tests comparing all probiotic treatments in their inhibition of both pathogens.
When compared against both pathogens, inhibition caused by single species (mean zone 9.9 cm) was greater than that of the mixtures (9.0 mm), although ANOVA showed that this did not reach significance (p = 0.237). L. plantarum was the non-significantly most inhibitory single strain. The 3-lactobacillus mixture was the most effective multi-species treatment, although again the difference did not reach significance (p = 0.219).
Broth inhibition assay
Testing against E. coli
Figure 5 shows the growth patterns for E. coli when incubated with non-pH-controlled probiotic supernatants. Table 2 indicates that all treatments caused significant (p < 0.001) growth inhibition of E. coli compared with pathogen-only culture, when the treatment was not pH-controlled.
Figure 6 shows growth of E. coli when incubated with the same probiotic treatments which were adjusted to neutral pH. In Table 2, it is seen that no pH-neutralised probiotic cultures caused significant growth inhibition of E. coli NCTC 9001.
Testing against E. faecalis
Figure 7 shows the growth patterns of E. faecalis when incubated with supernatants of the 8 probiotic treatments with no control for pH. The ANOVA results in Table 2 show that all treatments except for L. rhamnosus and the 3 Lb mixture showed significant inhibition of the pathogen under these growth conditions.
Figure 8 shows growth of E. faecalis when cultured with pH-neutralised probiotic supernatants. In these circumstances, none of the probiotic treatments displayed significant reduction in pathogen growth (Table 2).
Discussion
The first aim of this study was to assess the inhibitory ability of four single-strain and four multi-strain probiotic treatments. Results from the agar spot tests showed that all treatments were able to inhibit the growth of both pathogens, although there was variation between strains and mixtures. L. acidophilus was the most inhibitory single species against E. faecalis, which is consistent with the findings of McLean et al. [22] who tested 60 vaginal lactobacilli isolates for their inhibitory activity against BV-associated species.
Despite previously observed inhibition between component strains [29], mixtures were as effective at inhibiting pathogens as their single components as there was no statistical difference between mixtures and single strains in inhibition of either pathogen. It is worth mentioning that in our previous assays, L. acidophilus was the most inhibitory single strain [29]. It is feasible that if this strain was removed from the mixtures used here, it may result in the mixtures being less inhibitory than the single strains. This ability to inhibit growth, along with the breadth of activity of some mixtures shown in our previous study, suggests that the use of probiotic mixtures may be a more effective preventative method than single strains, since one treatment may be effective against several pathogens.
Results in Figs. 2 and 4, which show only weak associations between size of zone of inhibition and pH of the culture, suggest that acid production is not necessarily a critical element in the inhibition of either pathogen. Therefore, the prevention of pathogenic invasion may be largely due to other factors such as competition for nutrients and production by the probiotics of other antimicrobial compounds. This situation is somewhat complicated by the results from the broth inhibition assay (Figs. 7, 8) which suggest that pH does in fact play a role in the inhibition of both pathogens. This may in part be due to the different testing scenarios. In the agar spot test, live cells were used, whereas in the broth inhibition assay, only supernatants were incubated with pathogens. Since the supernatants used came from 24-h broth cultures, it could be that they contained greater concentration of acids than the viable cells in the agar spot test were able to produce on the agar plate.
Results from the broth inhibition assay showed that probiotic supernatants were able to inhibit the growth of urinary tract pathogens, particularly when the environment allows for the pH-lowering effect. This suggests that lowering of the pH produces conditions which are hostile to the growth of these 2 pathogens, and that this is an important factor since in none of the 16 pH-controlled tests did the probiotic treatment show significant inhibition compared with control.
The probiotic treatments for the broth inhibition assays were filter-sterilised supernatants rather than viable cells. This provides evidence that competition for nutrients in this in vitro environment, a potential mechanism in the agar spot test assays, is not the only mechanism involved since there are no organisms to compete with the pathogens in this assay. Instead, it is likely that during their overnight incubation, the probiotics produced bacteriocins, small antimicrobial peptides which can act towards other bacterial species with greater potency via such mechanisms as pore formation and inhibition of cell wall synthesis [33].
From Figs. 5, 6, 7, 8, it can be seen that the exponential phase of growth for the pathogens begins between 3 and 4 h after inoculation. In the case of both pathogens, this phase is delayed or reduced by the presence of the probiotic supernatant. Given that mean urination frequency is every 3 h [34], this suggests that probiotic bladder colonisation may reduce risk of urinary tract infection by delaying the onset of the exponential-phase growth of pathogens so that they may be excreted before this phase. However, some caveats are appropriate here. Firstly, this does depend on the ability of the probiotic to colonise the same area within that timeframe. Secondly, results from these in vitro assays cannot be fully extrapolated to the in vivo environment, given the multi-factorial nature of bacterial infection in the human body when compared with growth on an agar plate. For instance, one of the known mechanisms of probiotic action on UTI-causing pathogens is the enhancement of activation of NF-kappa-β and tumour necrosis factor-α within host bladder cells. Since in our study this mechanism is ruled out, the mechanisms above, postulated by Cadieux et al. [35], are likely to have caused inhibition here.
This study adds to existing evidence on the effect of probiotics on the risk of urinary tract infection. There have been few comparison studies relating the effects of single- and multi-strain treatments, especially at equal doses; however, in this study, we have shown that several species of lactobacilli can inhibit urinary tract pathogens, and that mixtures can be as effective as single strains at preventing growth. In a previous study [29], we showed that inhibition can occur between probiotic species within a mixture, although here the data show that despite this mutual inhibition, mixtures can still inhibit pathogens. Further to this, we have shown that it is not necessarily the presence of viable probiotic cells which causes such inhibition, since the cell-free supernatant, especially when it creates an acidic environment, can delay and reduce exponential-phase growth. However, it should be noted that normal bladder pH is 6.0 [36], and lowering this pH too far may lead to acidosis and therefore dysbiosis. The test organisms chosen for this study have been previously identified as potential urinary tract pathogens. Despite this, it is difficult to extrapolate our in vitro results to the in vivo environment due to the complexity of the in vivo location compared with the relatively simple in vitro medium.
References
Joint FAO/WHO Expert Consultation on evaluation of health and nutritional properties of probiotics in food including powder milk with live lactic acid bacteria (2001) Health and nutritional properties of probiotics in food including powder milk with live lactic acid bacteria. Food and Agriculture Organization of the United Nations, World Health Organization
Gotz V, Romankiewicz JA, Moss J, Murray HW (1979) Prophylaxis against ampicillin-associated diarrhea with a lactobacillus preparation. Am J Hosp Pharm 36(6):754–757
Winkler P, de Vrese M, Laue C, Schrezenmeir J (2005) Effect of a dietary supplement containing probiotic bacteria plus vitamins and minerals on common cold infections and cellular immune parameters. Int J Clin Pharmacol Ther 43(7):318–326
Sakamoto I, Igarashi M, Kimura K, Takagi A, Miwa T, Koga Y (2001) Suppressive effect of Lactobacillus gasseri OLL 2716 (LG21) on Helicobacter pylori infection in humans. J Antimicrob Chemother 47(5):709–710
Rosenfeldt V, Benfeldt E, Nielsen SD, Michaelsen KF, Jeppesen DL, Valerius NH, Paerregaard A (2003) Effect of probiotic Lactobacillus strains in children with atopic dermatitis. J Allergy Clin Immunol 111(2):389–395
Viljanen M, Savilahti E, Haahtela T, Juntunen-Backman K, Korpela R, Poussa T, Tuure T, Kuitunen M (2005) Probiotics in the treatment of atopic eczema/dermatitis syndrome in infants: a double-blind placebo-controlled trial. Allergy 60(4):494–500
Bibiloni R, Fedorak RN, Tannock GW, Madsen KL, Gionchetti P, Campieri M, De Simone C, Sartor RB (2005) VSL#3 probiotic-mixture induces remission in patients with active ulcerative colitis. Am J Gastroenterol 100(7):1539–1546
Venturi A, Gionchetti P, Rizzello F, Johansson R, Zucconi E, Brigidi P, Matteuzzi D, Campieri M (1999) Impact on the composition of the faecal flora by a new probiotic preparation: preliminary data on maintenance treatment of patients with ulcerative colitis. Aliment Pharmacol Ther 13(8):1103–1108
Rowland I, Capurso L, Collins K, Cummings J, Delzenne N, Goulet O, Guarner F, Marteau P, Meier R (2010) Current level of consensus on probiotic science–report of an expert meeting–London, 23 November 2009. Gut Microbes 1(6):436–439
Gibson GR, McCartney AL, Rastall RA (2005) Prebiotics and resistance to gastrointestinal infections. Br J Nutr 93(Suppl 1):S31–S34
Tejero-Sarinena S, Barlow J, Costabile A, Gibson GR, Rowland I (2012) In vitro evaluation of the antimicrobial activity of a range of probiotics against pathogens: evidence for the effects of organic acids. Anaerobe
Corr SC, Li Y, Riedel CU, O’Toole PW, Hill C, Gahan CG (2007) Bacteriocin production as a mechanism for the antiinfective activity of Lactobacillus salivarius UCC118. Proc Natl Acad Sci USA 104(18):7617–7621
Warren JW, Abrutyn E, Hebel JR, Johnson JR, Schaeffer AJ, Stamm WE (1999) Guidelines for antimicrobial treatment of uncomplicated acute bacterial cystitis and acute pyelonephritis in women. Infectious Diseases Society of America (IDSA). Clin Infect Dis 29(4):745–758
Salvatore S, Cattoni E, Siesto G, Serati M, Sorice P, Torella M (2011) Urinary tract infections in women. Eur J Obstet Gynecol Reprod Biol 156(2):131–136
Reid G, Charbonneau D, Erb J, Kochanowski B, Beuerman D, Poehner R, Bruce AW (2003) Oral use of Lactobacillus rhamnosus GR-1 and L. fermentum RC-14 significantly alters vaginal flora: randomized, placebo-controlled trial in 64 healthy women. FEMS Immunol Med Microbiol 35(2):131–134
Karlsson M, Scherbak N, Reid G, Jass J (2012) Lactobacillus rhamnosus GR-1 enhances NF-kappaB activation in Escherichia coli-stimulated urinary bladder cells through TLR4. BMC Microbiol 12(1):15
Darouiche RO, Thornby JI, Cerra-Stewart C, Donovan WH, Hull RA (2005) Bacterial interference for prevention of urinary tract infection: a prospective, randomized, placebo-controlled, double-blind pilot trial. Clin Infect Dis 41(10):1531–1534
Anukam KC, Osazuwa E, Osemene GI, Ehigiagbe F, Bruce AW, Reid G (2006) Clinical study comparing probiotic Lactobacillus GR-1 and RC-14 with metronidazole vaginal gel to treat symptomatic bacterial vaginosis. Microbes Infect 8(12–13):2772–2776
Anukam K, Osazuwa E, Ahonkhai I, Ngwu M, Osemene G, Bruce AW, Reid G (2006) Augmentation of antimicrobial metronidazole therapy of bacterial vaginosis with oral probiotic Lactobacillus rhamnosus GR-1 and Lactobacillus reuteri RC-14: randomized, double-blind, placebo controlled trial. Microbes Infect 8(6):1450–1454
Barrons R, Tassone D (2008) Use of Lactobacillus probiotics for bacterial genitourinary infections in women: a review. Clin Ther 30(3):453–468
Burton JP, Cadieux PA, Reid G (2003) Improved understanding of the bacterial vaginal microbiota of women before and after probiotic instillation. Appl Environ Microbiol 69(1):97–101
McLean NW, Rosenstein IJ (2000) Characterisation and selection of a Lactobacillus species to re-colonise the vagina of women with recurrent bacterial vaginosis. J Med Microbiol 49(6):543–552
Antonio MA, Rabe LK, Hillier SL (2005) Colonization of the rectum by Lactobacillus species and decreased risk of bacterial vaginosis. J Infect Dis 192(3):394–398
Ipek IO, Bozaykut A, Arman DC, Sezer RG (2011) Antimicrobial resistance patterns of uropathogens among children in Istanbul, Turkey. Southeast Asian J Trop Med Public Health 42(2):355–362
Reid G, Bruce AW, Fraser N, Heinemann C, Owen J, Henning B (2001) Oral probiotics can resolve urogenital infections. FEMS Immunol Med Microbiol 30(1):49–52
Reid G, Bruce AW (2001) Selection of lactobacillus strains for urogenital probiotic applications. J Infect Dis 183(Suppl 1):S77–S80
Reid G (1999) The scientific basis for probiotic strains of Lactobacillus. Appl Environ Microbiol 65(9):3763–3766
Reid G, Beuerman D, Heinemann C, Bruce AW (2001) Probiotic Lactobacillus dose required to restore and maintain a normal vaginal flora. FEMS Immunol Med Microbiol 32(1):37–41
Chapman CM, Gibson GR, Rowland I (2012) In vitro evaluation of single- and multi-strain probiotics: inter-species inhibition between probiotic strains, and inhibition of pathogens. Anaerobe 18(4):405–413
Chapman CM, Gibson GR, Rowland I (2011) Health benefits of probiotics: are mixtures more effective than single strains? Eur J Nutr 50(1):1–17
Shuler M, Kargi F (2005) Bioprocess engineering basic concepts, 2nd edn. Pearson Education, Singapore
Barbosa TM, Serra CR, La Ragione RM, Woodward MJ, Henriques AO (2005) Screening for bacillus isolates in the broiler gastrointestinal tract. Appl Environ Microbiol 71(2):968–978
Hassan M, Kjos M, Nes IF, Diep DB, Lotfipour F (2012) Natural antimicrobial peptides from bacteria: characteristics and potential applications to fight against antibiotic resistance. J Appl Microbiol 113(4):723–736
Fitzgerald MP, Stablein U, Brubaker L (2002) Urinary habits among asymptomatic women. Am J Obstet Gynecol 187(5):1384–1388
Cadieux PA, Burton J, Devillard E, Reid G (2009) Lactobacillus by-products inhibit the growth and virulence of uropathogenic Escherichia coli. J Physiol Pharmacol 60(Suppl 6):13–18
Hall JE (2010) Textbook of medical physiology, 12 edn. Saunders, Philadelphia
Acknowledgments
This work forms part of a PhD project funded by Probiotics International, Somerset, UK. Probiotics International had no role in the preparation of the article, study design, data collection, analysis, interpretation, or report writing.
Author information
Authors and Affiliations
Corresponding author
Rights and permissions
About this article
Cite this article
Chapman, C.M.C., Gibson, G.R., Todd, S. et al. Comparative in vitro inhibition of urinary tract pathogens by single- and multi-strain probiotics. Eur J Nutr 52, 1669–1677 (2013). https://doi.org/10.1007/s00394-013-0501-2
Received:
Accepted:
Published:
Issue Date:
DOI: https://doi.org/10.1007/s00394-013-0501-2